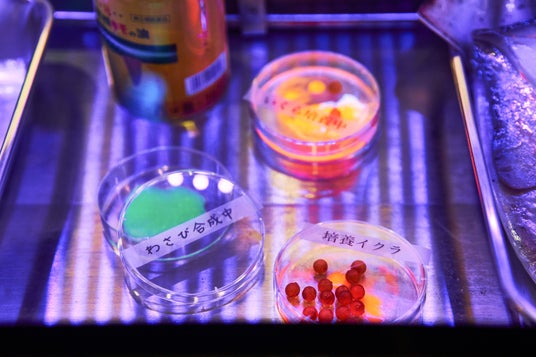

シビック・クリエイティブ・ベース東京[CCBT]2024年度アーティスト・フェロー5組による展覧会を都内各地で連続開催中。3月22日には全フェローが集合する活動報告会も開催!
2月28日(金)からは東京の住まいを3DスキャンするMVMNT、市原えつこによるディストピアをテーマとした展覧会をCCBTで同時期開催。

[右]市原えつこ「ディストピア・ランド」参考画像
シビック・クリエイティブ・ベース東京[CCBT](以下、CCBT)では、2024年度のアーティスト・フェローである布施琳太郎、HUMAN AWESOME ERROR(ヒューマン・オウサム・エラー)、柴田祐輔+Token Art Center(トークン・アート・センター)、MVMNT(ムーブメント)、市原えつこの5組による展覧会や上映会、パフォーマンス等のイベントを1月31日よりCCBTおよび都内各所にて開催しています。
2月末からは、東京の住まいの3Dデータを市民とともに集積し、現代のリアルなライフスタイルを考察するMVMNT(ムーブメント)、テクノロジーの発展の先に待つ未来像を提示し、ユーモアとフィクションを通して社会を生き抜く術を考察する市原えつこの展覧会をCCBTにて開催します。
本イベントは、クリエイターに新たな創作活動の機会を提供し、そのプロセスを市民(シビック)に開放することで、都市をより良く変える表現・探求・アクションの創造を目指すプログラム「アート・インキュベーション」の成果として発表するものです。1月31日から3月23日までの39日間に全5組のフェローが、5つの展覧会と32回のイベントを都内各所およびCCBTにて展開します。また、これらのプロジェクトの全貌を紹介する活動報告会を、3月22日に番組形式のイベントとして開催。2025年度のCCBTアーティスト・フェローの募集テーマについても発表予定です。
開催概要
シビック・クリエイティブ・ベース東京[CCBT]2024年度アーティスト・フェロー成果発表
参加作家:布施琳太郎、HUMAN AWESOME ERROR、柴田祐輔+Token Art Center、MVMNT、市原えつこ
会場:シビック・クリエイティブ・ベース東京[CCBT]、葛西臨海公園、コスモプラネタリウム渋谷、Salon de Zuppaほか
会期:2025年1月31日(金)~3月23日(日)入場無料
公式サイト:https://ccbt.rekibun.or.jp/core-programs/art-incubation/2024events
主催:東京都、シビック・クリエイティブ・ベース東京[CCBT](公益財団法人東京都歴史文化財団 アーツカウンシル東京)
公式ウェブサイト
1.CCBTアーティスト・フェローとは
クリエイティブ × テクノロジーで東京をより良い都市に変える表現・探求・アクションをつくり出す、国内最大規模となるアーティスト・フェロー制度
2022年度の開所以降、3期目を迎える「CCBTアーティスト・フェロー」は、CCBTを拠点に企画の具体化と発表、創作過程の公開やワークショップ等の活動を実施し、CCBTのパートナーとして活動しています。CCBTでは、制作費上限1,000万円のほか、制作スペースの提供や技術・マネージメントサポート、メンターをはじめとした専門家によるアドバイスなどを行っています。
昨年(2023年)度の同プログラムでは、ワークショップやレクチャー、展覧会の開催、街なかでのパフォーマンス等全45ものイベントを実施。延べ9,500人を超える参加者と交流し、アートとテクノロジーによる創造性を社会へと積極的に展開しました。
[2024年度のアーティスト・フェローと採択企画]XRによるツアー型展示、細胞の所有と倫理、渋谷特産代替食、ライフスタイルの3Dアーカイブ、未来のディストピア像 …… 5組のアーティストの活動から「これからの人間らしさ」を探る。
■市原えつこ
「ディストピア・ランド - テーマパークから国土へ:フィクションはどれだけ現実と接近できるか」
「最悪な時代に、人はどのように愉快に生きられるのか」という問いのもと、多様な問題を抱える社会をユーモアとフィクションを通して生き抜く術を検討し、虚実が入り混じる未来像を市民とともに構築するプロジェクト。

■柴田祐輔+Token Art Center(トークン・アート・センター)
「続・代替屋」
近代以降の日本食文化を構成する重要な要素である「代替」をコンセプトに、食べること、そして生きることについて探求するプロジェクト。大都市としての特有の生態系をもつ渋谷を舞台に、食に関する文化・歴史のリサーチを行い、本来の食材や料理法を代替した料理を創作する。

■HUMAN AWESOME ERROR(ヒューマン・オウサム・エラー)
「Super Cells Infinite」(スーパー・セルズ・インフィニット)
がんを患ったアーティストが、自身の細胞を題材にその所有や倫理、そこにある自己といった問題を提起するプロジェクト。展覧会では研究者や患者へのインタビュー映像を展示。これらの試みをDIYバイオのワークショップやトークにも展開する。

■布施琳太郎
「パビリオン・ゼロ」
日本現代美術の内側から「日本の大地=根拠(ground)とはなにか?」をあらゆる手段を通じて問いかけ、展覧会と上映、雑誌制作の3つの構成による新たなアートプロジェクト「パビリオン・ゼロ」を開催。

■MVMNT(ムーブメント)
「TOKYO[UN]REAL ESTATE」(トーキョー・アン リアル・エステート)
東京の多種多様な住まいと暮らしを3Dスキャンで記録し、等身大の人間らしさを記録・考察することで、現代社会の特質や変化を読み解く「考現学」に取り組むプロジェクト。

2.2月28日(金)からはMVMNT、市原えつこによる展覧会を開催
■2月6日(木)よりワークショップの申込受付を開始
詳細・申し込みについては公式ウェブサイトをご確認ください。
公式サイト:https://ccbt.rekibun.or.jp/core-programs/art-incubation/2024events
MVMNT「TOKYO [UN] REAL ESTATE」

市原えつこ「ディストピア・ランド - テーマパークから国土へ:フィクションはどれだけ現実と接近できるか」

3.全フェローが集合する報告会「CCBTスタジアム!」を開催。2025年度のCCBTアーティスト・フェロー、募集テーマも発表予定!
アーティスト・フェローと企画の具体化に伴走したメンターが集合し、本年度の活動を振り返る報告会を開催。進行役には、2000年代に多くのクリエイターを輩出したテレビ番組「デジタル・スタジアム(デジスタ)」のナビゲーターを務めた元NHK解説委員、アートディレクターの中谷日出氏を迎えます。各フェローのプレゼンテーションとともに、各プロジェクトの社会的意義を考察、解説する番組形式のイベントとして、活動の全貌を発信。さらに、本報告会では、CCBTアーティストフェローの次期募集テーマについても発表する予定です。
2024年度 CCBTアーティスト・フェロー 活動報告会「CCBTスタジアム!」
2025年3月22日(土)14:00~18:00
会場:シビック・クリエイティブ・ベース東京[CCBT]
※申込不要 ※YouTube配信あり
進行:中谷日出
プレゼンター:市原えつこ、柴田祐輔+Token Art Center、HUMAN AWESOME ERROR、布施琳太郎、MVMNT
登壇者(本プログラムメンター):宇川直宏(現“在”美術家、DOMMUNE 主宰)、清水知子(文化理論、東京藝術大学教授)、田中みゆき(キュレーター、プロデューサー)、水野祐(法律家/シティライツ法律事務所)

2023年度の活動報告会の様子

中谷日出(アートディレクター/東京国際工科専門職大学デジタルエンターテインメント学科教授)
広告映像アートディレクターとしてフリーで活動後、日本放送協会(NHK)に入局。アートディレクターとして「NHKスペシャル」長野オリンピック国際発信公式 映像監督、NHKロゴマークデザインをはじめ数々の作品を制作。NHK解説委員として科学文化芸術分野を担当し、番組「デジタル・スタジアム(デジスタ)」では多くのデジタルクリエーターを輩出した。現在、東京国際工科専門職大学デジタルエンターテインメント学科教授を務める。そのほか、ウェブTV「木曜新美術館」館長・ナビゲーター、Gマーク(グッドデザイン賞)グッドデザインフェロー、日本記者クラブ会員を務める。
4.フェローによる成果展示[1]
MVMNT
TOKYO [UN] REAL ESTATE■展覧会
TOKYO [UN] REAL ESTATE
「東京[不]不動産」
会期:2月28日(金)~ 3月9日(日)13:00~19:00
会場:シビック・クリエイティブ・ベース東京[CCBT]
※月曜休館

住まいの3Dデータを集積し、現代の東京にあるリアルなライフスタイルを考察。展覧会では、30件を超えるデータから、東京の暮らしを紹介するリアルとデジタルが融合した不動産屋がオープン!
東京の多種多様な住まいと暮らしを3Dスキャンで記録し、等身大の人間らしさを記録・考察することで、現代社会の特質や変化を読み解く「考現学」に取り組むプロジェクト「TOKYO [UN] REAL ESTATE」。
本プロジェクトでは、東京のリアルな居住空間を3Dスキャンし、デジタル時代の新しい”不動産”として記録・活用するため「お部屋の3Dデータ」を広く募集。データ提供と訪問撮影で集積したデータを、ウェブおよびCCBTでインスタレーションとして発表します。
本プロジェクトでは、これまでに自分の住まいを3Dスキャンする方法を学び、暮らしに関する対話を行うワークショップを実施し、市民とともにライフスタイルのデジタルアーカイブに取り組んできました。また、3Dデータを活用したマンガ制作に挑戦するワークショップでは、データをクリエイティブ・アセットとして活用する新たな共創の可能性を探求しました。
これらの活動の集大成となる展覧会では、集積した30件を超えるお部屋から、東京の暮らしを紹介する架空の不動産屋「東京[不]不動産」をオープン!様々な住まいのデータから、コロナ禍を経て取り戻した暮らしの様子、核家族の限界を感じた人々の共同生活など、東京のリアルなライフスタイルとその変化を発見することができます。

住まいの3Dデータ

キックオフイベント「暮らしのアーカイブレッスン」の様子

「TOKYO [UN]REAL ESTATE」ポップアップの様子(2024年12月)
■関連イベント
トーク「東京“宅話”~専門家と紐解く、暮らしにまつわるエトセトラ~」 ※申込不要
日時:3月1日(土)19:00~21:00
出演:原亮介(MVMNT)、瀬賀未久(MVMNT)、山田麗音(MVMNT)、岡本かなは(MVMNT)、ほか
■MVMNT(スペキュラティブ・デザインユニット)|ムーブメント

「20XX年の伝説を創造する」をミッションに、ありえるかもしれない未来の社会と文化をポップアップ&インストールし、未知のムーブメント=新たな伝説を生み出すスペキュラティブデザインの専門チーム。アートドリブンで思想性・社会性のあるコンテンツ(新たな意味・世界観、きっかけ)をプロトタイピングする。現代社会に新たな世界線を表出し、コミュニティの力でXS~XXXLまで創造的な社会運動を起こすことを目指している。
https://mvmnt.tokyo/
4.フェローによる成果展示[2]
市原えつこ
「ディストピア・ランド」■展覧会「ディストピア・ランド」
会期:3月1日(土)~16日(日)13:00~19:00
会場:シビック・クリエイティブ・ベース東京[CCBT]
※月曜休館

テクノロジーが進化した先に待つ世界はユートピアか、ディストピアか?
会期中には、レクチャーや食体験、未来社会を創造するワークショップまで多彩なイベントを開催!
日本の文化や習慣、信仰を独自の視点で読み解き、テクノロジーとの融合によって新たな価値観を提示してきた市原えつこが、CCBTアーティスト・フェローとして新たなプロジェクト「ディストピア・ランド」を展開。「最悪な時代に、人はどのように愉快に生きられるのか」という問いのもと、多様な問題を抱える社会をユーモアとフィクションを通して生き抜く術を検討し、虚実が入り混じる未来像を市民とともに構築します。
展覧会では、突然変異で一つ目に生まれたヤギを信仰する教団のイメージビデオ、苦難を生き抜いた市民たちによる民謡を踊り歌い続けるロボット、見たこともない生物など、奇想天外な未来の世界が描かれます。ディストピアの世界となったパラレルワールドを通して、人類の愚かさ、過去の厄災や困難を乗り越えてきたしぶとさを示し、より良い未来を共に考える場を創出します。
さらに、会期中には様々な分野の専門家を招いたレクチャーシリーズや、参加者と共に「ディストピアの市民生活」を想像、創作するワークショップも開催。未来の課題に備え、共にディストピア時代を力強く生き抜くメソッドを見つけましょう!

参考写真:市原えつこ「ディストピア・ランド」

参考写真:市原えつこ「ディストピア・ランド」
参考写真:市原えつこ「未来SUSHI」
■関連イベント レクチャーシリーズ「ディストピアの学校」 ※申込不要
ホスト:市原えつこ
[Day1]日時:3月8日(土)14:00~16:00
・「ディストピアの身体」
講師:田中みゆき(キュレーター、プロデューサー)、武田力(演出家、民俗芸能アーカイバー)
・「ディストピアの宗教」
講師:清水知子(文化理論、東京藝術大学教授)、海老原豊(SFライター・文芸評論家)
[Day2]日時:3月15日(土)14:00~16:00
・「ディストピアの国家」
講師:水野祐(法律家、弁護士(シティライツ法律事務所))ほか
・「ディストピアの市民生活」
講師:小沢剛(アーティスト)、畑中章宏(民俗学者)
※会期中にはワークショップも開催します。詳細は公式ウェブサイトでご確認ください。
■市原えつこ(アーティスト、妄想インベンター)|Ichihara Etsuko

Photo: Shino Chikura
アーティスト、妄想インベンター。日本的な文化・習慣・信仰を独自の観点で読み解き、テクノロジーを用いて新しい切り口を示す作品を制作する。奇想天外な発想で広く楽しめる作品性と日本文化に対する独特のデザインから、世界中の多様なメディアに取り上げられている。第20回文化庁メディア芸術祭エンターテインメント部門優秀賞、アルスエレクトロニカで栄誉賞を受賞。近年の主な展覧会に「六本木クロッシング2022展:往来オーライ!」(森美術館)等。
https://etsuko-ichihara.com/
5.参考:このほかのプロジェクトの開催日程
布施琳太郎、HUMAN AWESOME ERROR、柴田祐輔+Token Art Centerのプロジェクトでは、下記のイベントを開催予定です。申込の受付状況および詳細については、公式ウェブサイトにてご確認ください。
公式サイト:https://ccbt.rekibun.or.jp/core-programs/art-incubation/2024events
布施琳太郎「パビリオン・ゼロ」

HUMAN AWESOME ERROR「Super Cells Infinite」

柴田祐輔+Token Art Center「続・代替屋」

配信イベント

※内容は、都合により変更になる場合がございます。予めご了承ください。
企業プレスリリース詳細へ
PR TIMESトップへ